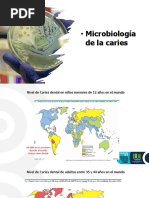

ESCUELA PROFESIONAL DE MEDICINA
4to ciclo
TEMA
Streptococcus viridans
EXPERIENCIA CURRICULAR
Fundamentos de Ayuda Diagnóstica I
DOCENTE
Dr. Barón Figueroa Juan Abelardo
INTEGRANTES
LLamoga Miñano, Maria Isabel
Olivares Rivera, Jennifer Estefani
GRUPO: 3P1
Trujillo - Perú
2019
I. INTRODUCCIÓN:
� Los estreptococos del grupo viridans (SGV) son habitantes normales de la mucosa oral,
respiratoria y gastrointestinal de los mamíferos y del tracto genital en la mujer, donde
juegan un papel importante en la prevención de la colonización de patógenos
potenciales. Las infecciones clínicas por SGV ocurren, mayoritariamente, tras una
lesión en las zonas de su hábitat normal. Es conocido que diversos microorganismos de
este grupo, como Streptococcus mitis, Streptococcus sanguis y Streptococcus mutans,
tienen la capacidad de producir dextranos extracelulares que actúan como mediadores
en los mecanismos de fijación, favoreciendo el establecimiento de nichos en diferentes
superficies como son, por ejemplo, los dientes y las válvulas cardíacas.
Son agentes etiológicos de diversos procesos patológicos de gran repercusión sanitaria.
Los SGV, y especialmente S. mutans, son los agentes más importantes implicados en
la caries dental que, sin ser una entidad que comprometa la vida, constituye una de las
patologías actuales más frecuentes y costosas, con una duración de por vida. Por otro
lado, el torrente sanguíneo puede ser invadido transitoriamente por los SGV tras un
traumatismo u otros procesos, que incluirían las manipulaciones dentales, cirugía del
tracto respiratorio superior (v.g., amigadalectomías), o cirugía e instrumentalización del
aparato genitourinario o del tracto intestinal. Por esta razón, en ocasiones, puede ser
difícil discernir sobre la significación clínica de la bacteriemia, especialmente cuando
sólo se obtiene un hemocultivo positivo. En la actualidad los SGV son responsables del
6-8% de los episodios de bacteriemias. Cuando estos microorganismos acceden al
torrente sanguíneo, las personas con válvulas cardíacas alteradas o pacientes con cáncer
y neutropenia presentan un riesgo elevado de infección grave que puede comprometer
la vida. Otro aspecto relevante es la diferente patogenicidad y afinidad orgánica de las
especies de SGV. El caso más destacable es el grupo Streptococcus anginosus/milleri
que tienen una clara tendencia por la producción de infecciones supuradas invasoras.
II. OBJETIVOS:
1. Analizar la morfología de Streptococcus viridans
2. Comprender la morfología y la patogenia del Streptococcus viridans
3. Comprender la evolución según la epidemiología de Streptococcus viridans
4. Identificar los factores de virulencia de Streptococcus viridans
III. MORFOLOGÍA:
� Los estreptococos viridans, también denominados estreptococos orales, poseen las
características comunes del género Streptococcus. Por lo tanto, se trata de cocos
grampositivos, anaerobios facultativos, asociados en parejas o cadenas, que no
producen catalasa y fermentan la glucosa con producción de ácido láctico. El término
viridans deriva del latín viridis, que significa verde, ya que producen, en su mayoría,
unas colonias pequeñas en agar sangre rodeadas de un halo estrecho de hemólisis verde
debido a una destrucción incompleta de los eritrocitos (hemólisis α).
Éstos comprenden muy diversas especies de estreptococos hemolíticos α y constituyen
un grupo heterogéneo de microorganismos que son causales importantes de la
endocarditis bacteriana. Se conocen diversas especies de estreptococos viridans, como
S. salivarius, S. mitis, S. sanguis y S. mutans, que forman parte de la microflora normal
de la boca, donde viven muy cerca de los dientes y las encías. Algunas especies
contribuyen a la aparición de las caries dentales.
IV. FACTORES DE VIRULENCIA:
Escasa patogenicidad , sin endotoxinas ni secreción de exotoxinas.
•Capacidad de adherencia a la fibronectina del endotelio valvular, del epitelio oral a
través del ácido lipoteicoico de su pared celular.
-Bacteremia: microorganismos en la sangre
-Adherencia: el microorganismo se adhiere al endotelio anormal o dañado a través de
adhesinas superficiales
-Colonización: proliferación del organismo junto con inflamación, que produce una
vegetación madura
V. PATOGENIA:
Se ha considerado que los estreptococos viridans tienen un bajo potencial patogénico y
que las infecciones clínicas ocurren después de su salida de su hábitat. Constituyen el
60 a 70 % de los miembros de la flora bacteriana de la boca, por lo cual después de una
extracción dentaria, por lo menos el 30 % de los pacientes tienen bacteriemia por
estreptococos viridans. Estos estreptococos, constituyentes preponderantes de la flora
del aparato respiratorio superior, son también los agentes causales más frecuentes de
las endocarditis bacterianas subagudas y se han aislado de infecciones de todos los
órganos y sistemas incluyendo el nervioso central, respiratorio, urogenital, músculo-
esquelético y de la piel. La asociación de especies del grupo viridans con la caries dental
y con la endocarditis está bien establecida. Se describe diferente frecuencia de
aislamiento de las especies de los estreptococos viridans, de acuerdo con la
� manifestación clínica, y así podemos citar a: Streptococcus sanguis I y II, Streptococcus
mitis y Streptococcus salivarius aislados de diferentes productos patológicos y los dos
últimos, asociados a endocarditis; al Streptococcus mutans, relacionado con la caries
dental; y al Streptococcus intermedius como agente causal de lesiones purulentas, tales
como: absceso cerebral, meningitis, absceso hepático y apendicitis
VI. MÉTODOS DIAGNÓSTICOS:
Se basa en la tinción de Gram y el cultivo de las muestras clínicas. La serología no es
[Link] que tener en cuenta la dificultad para la interpretación de un hemolítico
hemocultivo positivo para estafilococos coagulasa-negativos,ya que frecuentemente se
debe a contaminación a partir de la flora cutá[Link] ha estimado que solamente el 10-
25% de los hemocultivos positivos para estafilococos coagulasa-negativos reflejan
bacteriemia verdadera.
VII. EPIDEMIOLOGÍA:
Los estreptococos viridans constituyen una parte importante de la flora microbiana
normal del ser humano y de otros animales. Son autóctonos en las vías respiratorias
altas, el aparato genital femenino y todos los segmentos del tubo digestivo, pero son
más prevalentes en la cavidad oral. Por término medio, los estreptococos representan el
28-45% de la flora total cultivable en la cavidad oral. Gibbons y van Houten han
demostrado que esta distribución proporcional de las especies de estreptococos viridans
estaba determinada por su selectividad adherencia a los diferentes tejido orales.
Empleando las descripciones corregidas de las especies viridans, la ecología de las
cepas que habitan en la cavidad oral y la orofaringe pueden describirse actualmente
como sigue: en la mucosa oral se encuentra principalmente S sanguis, S. mitis y S.
oralis en la placa supragingival madura, S, Gordonii y en la placa subgingival, S.
anginosus.
En personas sanas, la adherencia de los estreptococos viridans puede proporcionar al
interior de la cavidad oral una “resistencia por colonización” que previene el
asentamiento de bacterias más patógenas, la fibronectina, un complejo glucoproteico
hallado en la superficie de las células epiteliales orales, promueve de forma selectiva la
adherencia de diversos cocos grampositivos. En ausencia o disminución de la
fibronectina, como sucede en pacientes con enfermedad crónica u hospitalizados,
aumenta la adherencia a las células del epitelio oral por parte de microorganismos como
pseudomonas aeruginosa. puesto que la colonización orofaríngea por parte de bacilos
gramnegativos entéricos precede a menudo a la invasión, la adherencia selectiva de los
� estreptococos viridans en la cavidad oral puede ser vista como un mecanismo protector
para el huésped.
VIII. CONCLUSIONES:
● Estreptococos viridians comprende diversas especies de estreptococos
hemolíticos alfa que son causales de endocarditis bacteriana.
● El Streptococos viridians es un gram positivo anaerobio facultativo que no
producen catalasa ni coagulasa;en agar sangre,sus colonias raramente son b
hemolíticos.
● Los Streptococos viridians son exigentes con respecto a sus necesidades
nutricionales ;para conseguir un crecimiento óptimo en cultivos primarios se
recomiendan agares y medios enriquecidos.
IX. REFERENCIAS:
1. Kenneth J. Ryan. C George Ray. Sherris Microbiología Medica. 5ta edicion.
Mexico: McGraw Hill. 2010
2. Brooks G. Carroll K, Butels Morse, mietznert. Jawetz, Melnick y Adelberg.
Microbiología Medica.25 edición. México: McGrawHill. 2011.
3. Barrero L. Microbiologia Clinica. Madrid: Editorial Sintesis SA. 2016.
4. Murray P. Rosenthalk, Psaller M. Microbiologia Medica. 8 edicion.
Barcelona: Elsevier. 2016.
5. Lopez L. Hernandez M. Colenc, Ortega S. Ceron G. Franco R. Las funciones
basicas en laboratorio de microbiologia. Investigación en Discapaciada. 2014.